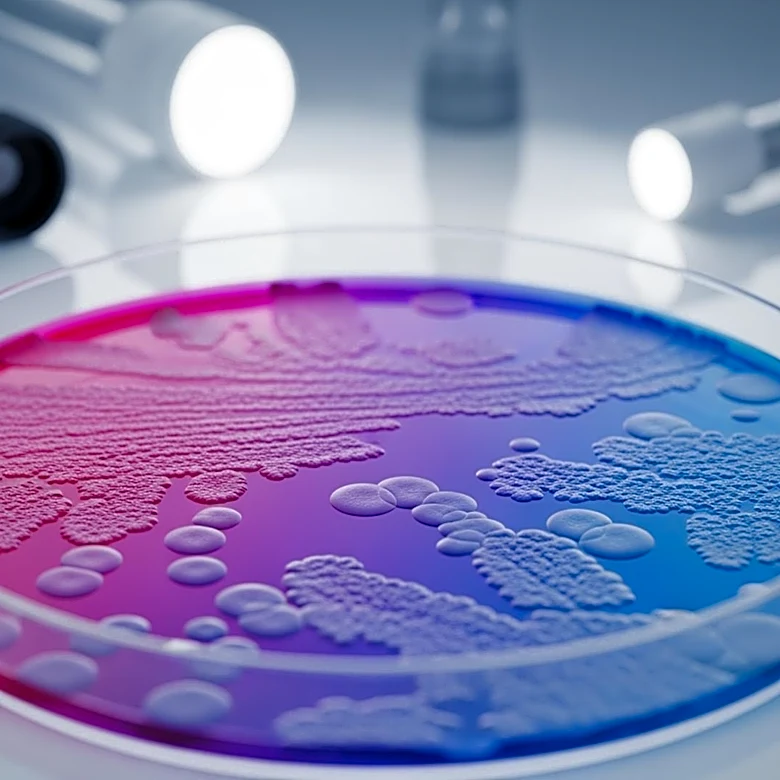
Gut Microbiome Analysis May Predict Parkinson's Risk Before Symptoms

What's Happening?
A new trend called 'bedtime stacking' is gaining popularity on social media, particularly among young women. Coined by TikToker Linnéa Pham, the practice involves going to bed early with a variety of tasks to complete, such as using a laptop, reading,
or journaling. While it may appear cozy and productive, experts warn that this habit could negatively impact sleep quality. The presence of screens and activities in bed can disrupt circadian rhythms and lead to poor sleep hygiene.
Why It's Important?
The rise of bedtime stacking reflects a broader cultural shift towards multitasking and maximizing productivity, even during rest periods. However, this trend poses potential health risks, as inadequate sleep can affect mental and physical well-being. The popularity of such practices underscores the need for greater awareness about the importance of sleep hygiene and the potential consequences of neglecting it. This trend may prompt discussions about balancing productivity with self-care and the role of social media in shaping lifestyle choices.
Beyond the Headlines
Beyond immediate health concerns, bedtime stacking highlights the influence of social media on personal habits and the pressure to conform to online trends. It raises questions about the sustainability of such practices and their long-term effects on lifestyle and health. As individuals increasingly seek validation through social media, there is a risk of prioritizing appearance over well-being. This trend may also reflect broader societal issues related to work-life balance and the constant connectivity facilitated by technology.